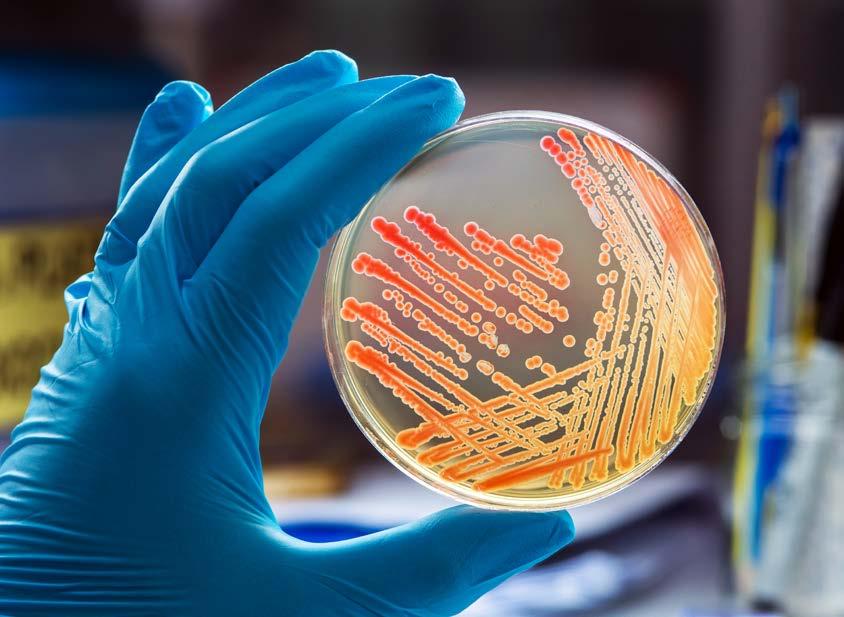

BIOLOGICAL SCIENCES
BOOKLET



General
Information
List of contact details in the Biological Sciences
Chairperson
Course Administrator
School of Biomedical Sciences
Animal, Plant and Environmental Sciences
Molecular and Cell Biology
Prof. Pieter De Maayer Pieter.Demaayer@wits.ac.za
Mrs Rayline Karim Rayline.Karim@wits.ac.za
Prof. William Daniels William.Daniels@wits.ac.za
Prof. Francesca Parrini Francesca.Parrini@wits.ac.za
Prof. Marianne Cronje Marianne.Cronje@wits.ac.za
Term Dates 2026
Activity
Start of Term
Dates
Tuesday, 03 February
First Teaching Block Tuesday, 03 February -Wednesday, 18 March (32 days)
Mid-term Vacation/Study/Research Break Tuesday, 19 March - Sunday 29 March (11 days)
Second Teaching Block Monday, 30 March - Tuesday, 19 May (33 days)
Study Break Wednesday, 20 May – Sunday, 24 May (5 days)
Examination/Assessment Period Monday, 25 May - Monday, 22 June (20 days)
Winter Vacation/Study/Research Break Tuesday, 23 June - Sunday, 19 July (27 days)
Third Teaching Block Monday, 20 July - Friday, 04 September (34 days)
Mid-term Vacation/Study/Research Break Monday, 07 September - Sunday, 13 September (7 days)
Fourth Teaching Block Monday, 14 September - Tuesday, 27 October (31 days)
Study Beak Wednesday, 28 OctoberSunday, 01 November (5 days)
Examinations/Assessment Period Monday, 02 NovemberFriday, 27 November (20 days)
Last Day of Term Friday, 27 November
Summer Vacation/Study/Research Break Saturday, 28 November
Academic Information
Introduction
Subjects taught within the Biological Sciences
Subjects taught within the Biological Sciences are offered by:
• School of Biomedical Sciences, Department of Anatomical Sciences
• School of Animal, Plant & Environmental Sciences (Ecology & Conservation, Biodiversity, Organismal Biology)
• School of Molecular & Cell Biology (Applied Bioinformatics, Biochemistry & Cell Biology, Genetics & Developmental Biology and Microbiology & Biotechnology)
• School of Biomedical Sciences, Department of Physiology
In addition, most schools offer Honours degree courses in their subjects; for details of these please consult the individual schools.
Biological Sciences –Undergraduate Computer Laboratory
Internet is required for many of the Biological Science courses, and it is advisable that all second- and third-year students register for the Nucleus Computer Laboratory early in the year with Mrs Rayline Karim in the Gate House Building, First Floor, Office/Room number 1.
Part-time courses
The Introductory Life Sciences BIOL1035A course equivalent is offered through Wits Plus for part-time students. Part-time students should register for both Introductory Molecular and Cell Biology MCBG1001A (a Semester 1 course) and Introductory Physiology and Environmental Sciences APES1003A (a Semester 2 course).
Curricula
The degree of Bachelor of Science shall extend over not less than three academic years of full-time study.
1. a course at first year level (level I) is denoted by the Roman numeral I following the descriptor and its code number begins with the Arabic numeral I (e.g. Chemistry I, CHEM1012A);
2. a course at second year level (level II) is denoted by the Roman numeral II following the descriptor and its code number begins with the Arabic numeral 2 (e.g. Chemistry II, CHEM2001A); and
3. a course at third year level (level III) is denoted by the Roman numeral III following the descriptor and its code number begins with the Arabic numeral 3 (e.g. Chemistry III, CHEM3034A).
A student is deemed to be:
a. in the 1st year of study if s/he has 0 credits or obtained credit for, courses at level I which do not make up a total of 108 credits
b. in the 2nd year of study until s/he has obtained a minimum of 108 credits at level I and 144 credits at level II
c. in the 3rd year of study until s/he has obtained a minimum of 432 credits, at least 144 of which are from level III.
Number of course credits in a current academic year of study
Unless permitted by the Senate*, a student shall include in her/his programme:
a. for the first year of study, courses for which no more than 144 credits at level I are allocated;
b. for the second year of study, courses for which no more than 192 credits at level II are allocated; and
c. for the third year of study, courses for which no more than 192 credits at level III are allocated.
*In exceptional cases, the Senate may permit a student in any year of study to register for additional courses.
Students are required to have one major in the Faculty of Science to graduate.
Prerequisites and compulsory courses
Course prerequisites
Many of the courses in the Biological Sciences have prerequisites which you must meet before you will be admitted to them. You will not be admitted to second year unless you have already passed Chemistry I, Auxiliary Mathematics and Introductory Life Sciences or equivalents.
Block course requisites
Some topics have prerequisites that apply even if you are not taking the whole of the course to which the block course belongs.
Compulsory and optional courses
Within the major courses, some subjects are COMPULSORY, and some are OPTIONAL. You must take ALL the compulsory courses for any course for which you are registered. You must then select which of the optional courses you wish to take in order to make up the 48 or 72 credits for the course. With the permission of the heads of schools concerned, you may be able to credit an optional course offered in another school.
Note: Details of courses, prerequisites and co-requisites for individual courses are given in the SCHOOL AND SYLLABUS INFORMATION section of this handbook.
Planning a degree curriculum
The second- and third-year Biological Science Major courses for which you may register are:
Biochemistry & Cell Biology III
Biodiversity II, III
Applied Bioinformatics III
Ecology & Conservation II, III
Genetics & Developmental Biology III
Human Biology III*
Human & Comparative Biology II*
Medical Cell Biology III*
Microbiology & Biotechnology III
Molecular & Cell Biology IIA*
Molecular & Cell Biology IIB*
Molecular & Cell Biology IIC*
Organismal Biology II, III
Physiology II, III*
* NOTE these courses have limitations on student numbers.

Choosing second-and third-year courses
The range of majors from which you can choose will be determined to some extent by the courses you have already passed – that is, by the course prerequisites you have met and by restrictions imposed by the timetables. You may only register for either Anatomy or Physiology but NOT both at third year level.
If you are registering for your second year of study, you must:
• Check that you have the necessary first-year prerequisites for the courses for which you intend to register.
• Check that you have included in your registration any courses that are compulsory.
• Check that the courses you register for will meet the prerequisites for the courses you eventually intend to register for in your third year of study.
• Check timetable clashes.
If you are registering for your third year of study, you must:
• Check that you have the necessary first- and second-year prerequisites and co-requisites for the courses for which you intend registering.
• Check that the courses for which you intend registering will allow you to complete your degree.
• Check timetable clashes.
Examining of courses (first, second
and third year)
Any course that has been completed in Semester 1, that is by the end of block 2, is examined in June during the mid-year examination period with the balance of the courses examined at the end of the year in October/November. The overall mark for a major course is the weighted average of the marks for all courses taken as part of that major. Students require a mark of 50% to obtain credit for course.
Sub-minima and exemptions
If you fail one or more of the courses within a major but obtain 50% or more for the major as a whole you will be credited with a pass for that major, providing that your mark for each of the courses you have failed is not less than the sub-minimum mark of 35%.
a. If you have obtained a mark of 50% or more for a major course as a whole but marks below the subminimum of 35% for one or more courses credited to that major, the following rules will apply:
i. If you have obtained marks below the sub-minimum in one or more courses within a major course, but in the other courses you have accumulated half or more of the total number of credits for the major, you will be required to repeat and obtain at least 50% in the failed courses the following year in order to receive credit for the major.
ii. If you have obtained marks below the sub-minimum in a course accounting for more than one quarter of the total credit number for the major, and have failed to accumulate half of the total number of credits for the major, you will be deemed to have failed the major as a whole regardless of your overall mark for the major.
iii. If you complete a course successfully for which you had previously obtained a subminimum, you will have completed the major.
b. If you obtain less than 50% for a major as a whole then the following rules will apply:
i. If you fail the major but have passed courses that comprise half the point value for the course you will be exempted from repeating those courses.
ii. A student repeating a major/ course is required to repeat both the theoretical and practical components.

Amendments to registration
Any change in second and third-year courses must be made by the end of the first week of the academic year. A course may be cancelled at any time up to the beginning of September of the current year of registration. After that date you will be considered to still be registered for the course and will be marked “failed absent” in the end-of-year examinations if you do not complete the course.
COURSE CHANGES can be made at various times during the year as follows:
1. A course may be cancelled at any time prior to the end of the first week of the block in which the course is offered.
2. An amendment to course registration which involves the addition of a short-course must be made before the end of the first week of the block in which the shortcourse is offered. This provision is subject to the approval of the heads of the schools concerned. The addition of any shortcourse is subject to the condition that it does not cause a clash with any existing short-course on the examination timetable.
3. If you have failed a course which is not compulsory, you may, if you wish, register for an additional course in order to replace the one you have failed.
Course registration amendment forms are obtainable from the Faculty of Science Office, Ground Floor, Mathematical Building, West Campus. These forms must be completed, and the change signed by the Head of the School (or nominated representative) for the short-course which you are changing.
Prizes
There are prizes for top students in all disciplines of the Biological Sciences. Please consult the administrator in each school for details.
School and Syllabus Information
Interschool Course
The Biological Sciences offers one course in Biology at the first-year level, Introductory Life Sciences, which is run jointly by the School of Animal, Plant and Environmental Sciences (incorporating Ecology & Conservation, Biodiversity, Organismal Biology) and School of Molecular and Cell Biology, (incorporating Biochemistry & Cell Biology, Genetics & Developmental Biology, Microbiology & Biotechnology and Applied Bioinformatics). This course has been designed to cover the broad spectrum of modern biology and provide students with an opportunity to learn about the diverse fields available, before making more specialised choices at second year level. Introductory Life Sciences I includes material which we feel is essential for all biologists.
Introductory Life Sciences (ILS)
BIOL1035A INTRODUCTORY LIFE SCIENCES 1 (36 credits) (Slot B or D)
Introductory Life Sciences is a foundational biology course for any student wishing to continue in the biological sciences, whether it be molecular and cell biology; animal, plant, and environmental sciences; physiology or anatomy. The course will cover the building blocks of cells including cell biology, biochemistry and genetics. The course will then follow the organisation of living organisms from the cell to whole organisms, studying life in its diversity, evolution, and the biology (structure and function) of various groups of organisms including protists, animals, and plants. The course will explore how organisms interact within a system and their need for conservation. BIOL1035A is a restricted course that only accepts 420 students a year.
School Courses
(At second- and third-year levels)
School of Biomedical Sciences, Department of Anatomical Sciences
The Department of Anatomical Sciences offers a diverse array of courses, reflecting the research interests of the staff members. The Department is well known for its strengths in biological anthropology (skeletal biology, forensic anthropology, human growth and development, comparative anatomy and palaeoanthropology), comparative vertebrate anatomy, developmental biology (including aspects of teratology), neuroanatomy, and medical cell biology (in the field of cancer and toxicology in various organ systems). Two separate courses are offered to train scientists in broad but distinct fields of human biology and medical cell biology.
Second year courses
ANAT 2021A HUMAN AND COMPARATIVE BIOLOGY II (48 credits) (Slot E)
Notes for the guidance of students:
1. Entrance to this second-year course is restricted and applicants are selected on the basis of merit with a limit on the number of students who can be accepted.
2. The course is required for students intending to proceed to Human Biology III or Medical Cell Biology III.
Prerequisites: Introductory Life Sciences I (BIOL 1035A) AND Chemistry I (CHEM1012A - major) AND either Auxiliary Mathematics I (MATH 1041A) OR Algebra I (MATH1034A) AND Calculus I (MATH1036A) OR Physics I (PHYS1035A – major) OR Auxiliary Physics (PHYS1001A)
Human and Comparative Biology II is a full course at the second-year level of study. The course consists of four broad topics that aim to clarify and explain the structure of the human body within a comparative framework of the evolutionary history and development of vertebrates. The primary goal of the course is to promote an understanding of the evolutionary history and adaptations of the human body within the broader context of the anatomical form and function of other vertebrate species. Interactions of organisms with the external environment, combined with evolutionary mechanisms over time have resulted in the development, adaptation, retention, and loss of features that have yielded an incredible diversity of form and function among all the vertebrate species, including humans. To begin to appreciate how these evolutionary mechanisms have worked overtime this course emphasizes a comparative perspective across the vertebrates in order to understand how adaptation and selection have shaped the anatomy of modern humans at the gross and cellular level. The course is a stepping-stone to the Human Biology III (ANAT 3002A) and Medical Cell Biology (ANAT 3011A) courses offered in the third year of study.

Concepts of Evolution, Primary Tissues, and Early Embryology
This is an introduction to the basic principles of evolution, comparative anatomy and embryology as they apply to the study of human biology. Lectures will cover evolutionary theory, adaptation, morphological concepts, and the evolutionary history of vertebrates. Basic tissue morphology and histology will be covered as an introduction to teaching in blocks 2 and 3. Embryology will be presented as a tool for discerning the unitary origin of life, and as a mechanism for evolutionary change. Topics will include early embryonic development and gametogenesis, comparative embryology, and embryological development of the integumentary system.
Comparative Biological Systems
This topic covers a series of integrated study areas. It is a theoretical and practical topic that introduces students to the basic knowledge of primary tissues and selected bodily systems placed within an evolutionary developmental framework. These systems include bone and osteogenesis, the lymphatic system, and the male and female reproductive systems.
Vertebrate and Human Neuroanatomy
This topic extends over the entire third block and will cover in detail the neuro-anatomical structures and evolution of the vertebrate brain, focusing on the human brain. This structural knowledge will be related to functional aspects of the brain and how structure and function combine to form the behaviors and neural phenomena of everyday life. Examples such as emotional reactions and the conscious experience will be explored.
The Vertebrate Skeletal System
The vertebrate skeleton is fundamental to comparative anatomy, with the human skeleton specifically forming the basis of biological anthropology. The topic focuses on human and comparative osteology by examining the evolutionary factors underlying morphological differences among vertebrates. Students will acquire the basis for understanding functional anatomy as well as the osteological fundamentals for further study in fields such as forensic (biological) anthropology and human variation.
Third year courses
ANAT3002A HUMAN BIOLOGY III (72 Credits) (Slot D)
Prerequisites: Human & Comparative Biology II (ANAT2021A) OR Anatomy II (ANAT2020A)
Human Biology III is a third-year course designed for students with an interest in biology, zoology, palaeontology, and biological anthropology. This course consists of four lecture topics and one research component for a total of 72 credits. It provides an in-depth coverage of topics in human biology and evolution through lecture content and independent student work. At the same time, this course provides the basic foundations for scientific research and requires that each student design a research proposal under the supervision of academic staff in the Department of Anatomical Sciences. The following topics are covered in the course:
1. Human Skeletal Biology
An introduction to the application of human skeletal biology principles, including assessment of skeletal age and development, morphological and metric assessment of sex, population affinity, stature and facial identification. Analysis of unique skeletal markers such as trauma and pathology as well as forensic archaeology and taphonomy will also be introduced.
2. The Human Legacy
Explores the basic themes underlying human evolutionary biology including our place in the natural world, the shift to bipedality, development of the human brain with its capacity for behavioral complexity, symbolic thinking and language, the expansion out of Africa and the diversity of early human biological adaptations.
3. Human Biodiversity
Basic concepts and the history of methods for documenting human biodiversity are presented together with new approaches to understanding patterns of human biological variation ranging from the molecular to the population level. Other topics include human environmental adaptation, the role of culture and behaviour in human diversity, and the spectrum of race and biological determinism in the 20th century.
4. Research Methods
A short yet intensive course that focuses on the scientific method and its application, hypothesis construction, research ethics, and quantitative approaches to testing hypotheses. Designed to prepare students for their research proposals and as a basis for further research in science. A brief hands-on introduction on how to effectively and responsibly use generative AI in the workplace and research is also included in this section.

5. Research Proposal
The research component is designed to give students the experience of identifying potential gaps in scientific literature and developing a research project. Working in small groups, students will pursue a research topic under the supervision of an academic staff member from the Department of Anatomical Sciences. They must formulate a research proposal detailing a specific research question, the relevant literature, the proposed study design, data analysis, and expected outcomes. The research proposal is required for each student, in the form of a final written report, and the individual proposals are also combined and presented orally by the group.
ANAT3011A MEDICAL CELL BIOLOGY III (72 credits) (Slot B)
Medical Cell Biology III (ANAT3011A) is a course at level III. The course consists of 6 topics that aim to give students an understanding of the cellular and molecular structure and function of the human body within a biomedical framework, reflecting the current research interests of the Department. The course provides coverage of issues related to cell structure and function, developmental biology and applied cell biology through lectures and independent student work. Course content is selected primarily from research articles in order to convey current developments in specific fields, with laboratory sessions aimed at introducing students to commonly used and cutting-edge research and diagnostic techniques. The course thus aims to prepare students for post-graduate studies and employment in the scientific arena. The following topics are covered in the course:
1. Teratology and birth defects
Birth defects occur in approximately 3-6% of all newborns. It is now known that environmental-genetic interactions and synergistic interactions of teratogens are some of the causes of birth defects; however, exposure to multiple pharmaceutical, industrial and agricultural chemicals makes it difficult to accurately estimate risk. After Thalidomide (a drug used for morning sickness in the 1960s) induced birth defects it became widely accepted that the developing embryo could be susceptible to agents that have negligible or non-toxic effects on adults. To date, 6 major teratogenic mechanisms have been established: folate antagonism, neural crest disruption, endocrine disruption, oxidative stress, vascular disruption and specific receptor or enzyme-mediated teratogenesis. This topic gives students a basic understanding of the factors leading to abnormalities and defects in physiological development.
2. Introduction to toxicology
Toxicology is the science of chemical hazards, safety and margin of usefulness. The overall focus of toxicology science is to identify potential harmful effects of chemical compounds to humans, animals and the environment, and to provide for their prevention and treatment. Toxicology is a multidisciplinary science based upon Physiology, Biochemistry, Molecular Biology, Chemistry, Pharmacology, Pathology, Epidemiology and several others. This topic will introduce the student to principles of toxicology, identification and characterization of toxins and determination of their fate in the body, and evaluation of toxicosis.
3. Introduction to cellular and molecular neuroscience
The brain is composed of billions of neurons – the basic functional units of the nervous system – connected to each other and capable of transmitting signals at speeds of 100m.s, allowing organisms to process and respond to any changes in their environments rapidly. This topic will introduce students to the basic principles of cellular and molecular neuroscience which involves the study of neurons at a cellular and ultrastructural level as well as the mechanism by which they express and respond to various signals. This topic will also explore the mechanisms underlying structural plasticity, learning and memory as well as the cellular and molecular basis of several well-known neurological diseases and disorders.
4. Cellular and molecular mechanisms of cancer
This topic presents cancer as an aberration of normal cellular and molecular processes. Students will be exposed to the epigenetic and genetic contributions to tumour initiation as well as mechanisms of tumour progression in relation to evasion of cell cycle control mechanisms and immunity. Current biomedical treatments (for tumour eradication and palliation) will be discussed in relation to their mechanism of action. The background to which lectures will be set is one of experimental design and an understanding of applications in the field of cancer research.
5. Cardiovascular biology and histopathology
The cardiovascular system comprises of the heart and vessels. It is found in all organs and tissues as it is often the first point of contact for pathogens, treatment, toxins, and teratogens. This topic will unpack the basic structure and mechanisms in the cardiovascular system and explore adaptive features of the cardiovascular system in metabolic syndrome and common cardiovascular conditions. Student will examine the role of the heart and vasculature in respiration, excretion, homeostasis, metabolism, and reproduction.
6. Research proposal
Students will have an opportunity to compile a research proposal related to a particular topic taught during the year. Project choice is usually based on individual interests, providing the proper distribution among the class is fulfilled. Students will be taught to identify research questions, construct hypotheses, design investigative studies and data collection strategies, conduct analyses of data, and interpret findings. This topic includes basic experimental design, writing, reading and presentation of research reports and sampling techniques.

ACADEMIC STAFF
BACCI, N
BILLINGS, B
BOTHA, D
BRITS, D
BScHons MSc PhD (Witwatersrand) Senior Lecturer
BScHons MSc PhD (Witwatersrand) Senior Lecturer
BSc Hons MSc (Pretoria) PhD (Witwatersrand) Lecturer
BScHons MSc (Pretoria) PhD (Witwatersrand) Associate Professor
JOHNSON, J MSc PhD (Witwatersrand) Lecturer
LOTTERING, T BSc Hons MSc (Witwatersrand) Lecturer
MALUNGO, I
BSc Hons MSc PhD (Witwatersrand) Lecturer
MANGER, P BSc Hons PhD (Queensland) Professor
MBAJIORGU, E PhD (University of Limpopo) Professor
MEYER, A
NGWENYA, A
NTULI, S
BA Hons BSc Hons MSc (Pretoria) PhD (Witwatersrand) Senior Lecturer
BScHons PhD (Witwatersrand) Senior Lecturer
BSc Hones, MSc (Pretoria) Lecturer
RAMPHALENG, T BSc Hons MSc PhD (Witwatersrand) Lecturer
TSHABALALA, T BSc Hons MSc PhD (Witwatersrand) Lecturer
XULU, K
BSc Hons MSc PhD (Witwatersrand) Senior Lecturer
School of Animal, Plant and Environmental Sciences (AP&ES)
The aim of the School of Animal, Plant and Environmental Sciences is to provide high quality teaching and research within its theme of The Biology of a Changing World: Conserving African Biodiversity.
The staff of the School of Animal, Plant and Environmental Sciences recognise that most students enter university with some idea of the career they want to pursue. This in turn influences their choice of subjects and topics. We have therefore organised our topics into two “Career Lines”. However, it is important to remember that it is NOT necessary to specialise to any great extent at the undergraduate level as this degree is designed to provide a broad base for future career paths. Students will be able to change direction at a later stage should they so wish. We also believe that a degree should give you not only knowledge about the subject but also the skills and attitudes to be used in any career, especially the ability to think critically and solve problems.
Possible fields of employment requiring a degree from the School of Animal, Plant & Environmental Sciences:
Nature Conservation: National or conservation agencies, private wildlife enterprises, environmental NGOs, environmental consultancy
Research: In government and university institutions, e.g. Council for Scientific and Industrial Research (CSIR), Department of Agriculture, Department of Water Affairs and Forestry, Department of Sea Fisheries, Agricultural Research Council (ARC), Veterinary Research Institute, medical and biological departments at universities
Environmental Impact Assessment: Legislation now requires most developments to have an Environmental Impact Assessment done, which has provided huge career and business opportunities for zoologists, plant scientists and ecologists.
Museums: Ditsong National Museum of Natural History is one example, South African National Biodiversity Institute, including the National Herbarium, another. There are many others.
Education: High school teaching, universities, universities of technology, corporate training
Scientific Journalism: Newspapers, journals, broadcasting, natural history documentaries.
Commerce: Private consulting firms, environmental divisions of large corporations, marketing, scientific services, mining and forestry companies
Industry: Numerous industries are concerned with research and development and supply of biological products and materials.
Law, Commerce & Medicine: A basic BSc degree forms an excellent first degree for any of these professions.
Career Lines:
Two broad career lines, each corresponding to a major, are offered in the School: (i) Applied Ecology and Global Change (ii) Biodiversity in a Changing World
Students are encouraged to discuss their careers and selection of Majors as well as the courses these comprise of with staff members.
Notes to guide students:
1. Begin by defining your areas of interest. You will then find that the courses fall into natural categories. Furthermore, you will be able to select other appropriate co-majors in the Biological Sciences or other subject areas in the Faculty of Science.
2. Each Major comprises a number of courses, to make up 48 credits at second year and 72 credits at third year.
3. Students wishing to specifically pursue a career in biological sciences are strongly advised to proceed to the Honours degree. An Honours degree offers greater opportunities for employment and is required for registration as a Natural Scientist.
4. The exam mark will usually be 40 percent of the final mark for undergraduate courses. Any material that is available for scrutiny by the external examiner can contribute to the exam mark.
5. The timetable for 2026 is on page 24 and advice is available in Room B114 or via the Course Administrator, Mrs Rene Gilbert (Rene.Gilbert@wits.ac.za).
6. Admission requirements/prerequisite units
All APES 2nd year courses
All APES 3rd year courses
Chemistry I
Introductory Life Sciences I or equivalent Ancillary Mathematics I or equivalent
2nd year APES courses with a minimum 48 credits per major. PLEASE NOTE THAT THIRD YEAR COURSES NEED PARTICULAR PRE- AND COREQUISITES. SEE DETAILS BELOW.
Basic Statistics for the Natural Sciences II (STAT2013) or equivalent
7. Recommended first year subjects include Complementary Life Sciences I, Geography I and Geology I.
Composition of the Major
You must make up the required credits by taking courses in 2nd and 3rd year. See the timetable on page 21 to plan your curriculum.
Applied Ecology and Global Change III
Objective
This focus area provides students with insight into the quantitative study and use of ecological, eco-physiological and systematic principles in the context of ecology, conservation and environmental science and its applications in conservation biology and environmental management.
Recommended Courses
Second Year – Total of 48 credits per major
Ecology, Environment and Conservation IIA (24 points)
Ecology, Environment and Conservation IIB (24 points)
Life on Earth: Diversity II (24 points)
Life on Earth: Evolution II (12 points)
Third Year – Total of 72 credits per major
Applied Ecology and Global Change IIIA: Individuals, Populations and Communities (30 credits)
Applied Ecology and Global Change IIIB: Managing our Complex World (30 credits)
Practical Skills in Animal, Plant and Environmental Sciences III (12 credits) OR
Research Methods in Animal, Plant and Environmental Sciences III (12 credits)
Biodiversity in a Changing World III
Objective
This exciting focus area provides students with the appropriate skills, knowledge and attitudes that would allow them to enter a wide range of zoological, botanical and ecological careers and to provide a foundation for future specialisation.
Recommended Courses
Second Year – Total of 48 credits per major
Animal Form and Function II (24 points)
Plant Form and Function II (24 points)
Life on Earth: Diversity II (24 points)
Life on Earth: Evolution II (12 points)
Third Year – Total of 72 credits per major
Biodiversity in a Changing World IIIA: From Process to Pattern (30 credits)
Biodiversity in a Changing World IIIB: From Physiology to Behaviour (30 credits)
Practical Skills in Animal, Plant and Environmental Sciences III (12 credits) OR
Research Methods in Animal, Plant and Environmental Sciences III (12 credits)
Information for all prospective biology teachers
Please note that any student who wishes to do a PGCE (Postgraduate Certificate in Education) to teach Life Sciences must have completed three years in any field of biology and have majored in biology. In addition, you must complete a first-year unit in each of two learning areas in order to qualify to teach those learning areas to Grade 9 (see School of Education for further details). Liaise with the School of Education for clarity on the appropriate courses to be completed.
Details of courses:
Second Year
Students must register for a total of 144 credits from all courses, comprising of 48 credits in each of three majors, two of which must be completed in the School including Basic Statistics.
Basic statistics for the Natural Sciences (STAT2013A) (12 credits) is compulsory. This course is a prerequisite for all 3rd year APES courses.
APES2033A ANIMAL FORM AND FUNCTION II (24 credits)
This course examines how the anatomy and physiology of living and extinct animals have been shaped through evolutionary processes for functional purposes. Using a set of fundamental principles (e.g., lever mechanics), the course builds integrative knowledge of animal anatomy, functional morphology, and comparative physiology. This course is a pre-requisite for the 3rd year Biodiversity in a Changing World Major (APES3078A and APES3079A)
APES2038A RESEARCH METHODS IN BIOLOGICAL SCIENCES II (12 credits)
This course provides students with an opportunity to gain experience in research methods. The course consists of a self-study topic in which students engage with particular staff members about a research topic of interest, and learn how to develop the research problem statement, aim and objectives. The student learns how to perform literature reviews, research appropriate methods, conduct the research and write a report. The course will have a strong focus on research methodology and skills development (writing and presenting, data collection and analysis). THIS COURSE MAY ONLY BE TAKEN UNDER EXCEPTIONAL CIRCUMSTANCES AND WITH THE APPROVAL OF THE HEAD OF SCHOOL.
APES2039A ECOLOGY, ENVIRONMENT, AND CONSERVATION IIA (24 credits)
The course is a comprehensive but introductory survey of the main topics in ecology, designed to have an African perspective, and to serve the needs of terrestrial, freshwater, and marine ecology. It covers the fundamental components of all scales of ecology, including organismal, community, population, ecosystem, landscape, and global ecology. This course is a pre-requisite for the 3rd year Applied Ecology and Global Change Major (APES3082A and APES3083A
APES2040A ECOLOGY, ENVIRONMENT, AND CONSERVATION IIB (24 credits)
The course builds on Ecology, Environment, and Conservation IIA. In Ecology, Environment, and Conservation II the foundational concepts of ecology covered in the first semester course are applied to the management and conservation of systems. Humans can no longer be viewed as separate to the environment, and this course explores how people manage natural resources, including the management of wastewater and its effects on the environment, sustainability in transformed ecosystems, and the concepts of resilience and stability. We will also engage with topics around conservation biology, including theory, legislature and conservation needs and threats in the 21st century. This course is a pre-requisite for the 3rd year Applied Ecology and Global Change Major (APES3082A and APES3083A)
APES2041A PLANT FORM AND FUNCTION II (24 credits)
The purpose of this course is to demonstrate how the structure of plants has allowed them to survive on planet Earth and ultimately enable other life forms, including humans, to survive. Plant Form and Function will introduce students to the organization of the plant body, describe the function of plant tissues and discuss plant nutrition and water uptake. The main objective is to provide an integrated understanding of how plants function under changing environmental conditions and present the fundamental concepts important for the understanding of plant growth which will enable accurate estimates of plant productivity to be made for future climates. The practical sessions will complement the material covered in the formal lectures and will introduce students to important aspects of plant physiology. This course is a prerequisite for the 3rd year Biodiversity in a Changing World Major (APES3078A and APES3079A)
APES2042A LIFE ON EARTH: DIVERSITY II (24 credits)
This course introduces students to the major groups of flora and fauna in grassland and savanna (the major biomes that occur in Gauteng Province) in the contest of the principles and practices of systematics. The course focuses on the evolutionary trends in morphology, physiology, ecology and/or behaviour, and the biogeographical features that have shaped the complements of organisms occurring in this region. In this way, drivers of biodiversity and the economic/ecological conservation values of this biodiversity is addressed, and the impact of human transformation on the biota is also considered. This course lays the foundation for biosystematics, evolutionary and ecological work by familiarizing students with many of the components and factors affecting biodiversity. In addition, it introduces students to the technological advances in the archiving of such pertinent biodiversity information. This course is a pre-requisite for ALL 3rd year courses (APES3078A, APES3079A, APES3082A and APES3083A)
APES2043A LIFE ON EARTH: EVOLUTION II (12 credits)
This course provides a working understanding of evolution. It introduces Darwinian natural selection and contextualises it in neo−Darwinian population genetics. Examples are drawn across the diversity of life on earth, from organelles to plants, animals and humans. Topics include macro−evolution, micro−evolution, speciation, evolution of sex, and strategies for improving fitness. This course is a pre-requisite for ALL 3rd year courses (APES3078A, APES3079A, APES3082A and APES3083A)
Third year courses
Students must have passed STAT2013A or equivalent to register for third year courses.
Students can take double APES majors or a major in APES and other Schools, provided they have the entry requirements to study at third year. Students must register for a total of 144 credits from all courses, comprising of 72 credits per major. This course is a prerequisite for ALL 3rd year courses.
APES3078A BIODIVERSITY IN A CHANGING WORLD IIIA: FROM PROCESS TO PATTERN (30 credits)
This course builds on foundational concepts in evolution and diversity, exploring what comprises biodiversity at multiple levels. Starting at the molecular level, the class will explore the origins of life on earth and cellular evolution, then the evolutionary relationships between organisms through phylogenetics and systematics. This then leads us to the study of biogeography, considering how the distributions of species were established. Finally, the course covers evolutionary processes at the genetic level to understand what biodiversity is, and ultimately how to conserve biodiversity. This course is a co-requisite for the APE3079A.
APES3079A BIODIVERSITY IN A CHANGING WORLD IIIB: FROM PHYSIOLOGY TO BEHAVIOUR (30 credits)
The course builds on the concepts taught in Biodiversity in a Changing World IIIA: From Process to Pattern. The course explores how the physiology of plants and animals allows them to survive and adapt in a changing world, with a view to best conserve biodiversity. The course also covers proximate and ultimate aspects of animal behaviour with a focus on conservation. Plant/animal interactions are explored within the theme of biological control, and the impact of alien invasives in conserving biodiversity.
APES3082A APPLIED ECOLOGY AND GLOBAL CHANGE IIIA: INDIVIDUALS, POPULATIONS AND COMMUNITIES (30 credits)
In this African-centric course topics in ecology, spanning from the individual to the biological community will be covered. Topics range from the evolution of traits, functional traits, behavioural ecology, population dynamics, and how these contribute to community structure, species co-existence, change in species composition, and the broader consequences of these processes (succession and alternate states). The course has a strong quantitative component to teach students how to think in a structured manner and to work with mathematical models and complex datasets. This course is a co-requisite for the APE3083A.
APES3083A
APPLIED ECOLOGY AND GLOBAL CHANGE IIIB: MANAGING OUR COMPLEX WORLD (30 credits)
The African-centric course begins with a paleo-ecological focus to understand historical global environmental change and provide the context for our complex world. The course provides an integrated knowledge of contemporary environmental issues related to global change and its implications for biodiversity, ecosystem services and human wellbeing. The course explores the complexity of natural systems, aspects of landscape management, conservation, society, and ecosystem services. The course has a strong quantitative component to teach students how to work with large amounts of complex data.

Please note that in addition to these 3rd year courses you must take one of the elective courses listed below, some of which are field trips. At the beginning of each semester, it is your responsibility to find out when the field trips take place.
APES3084A Practical Skills in Animal, Plant, and Environmental Sciences III (12
credits)
This field course gives students experience in doing practical research in a terrestrial or aquatic environment. The course includes learning methods for conducting a research project including formulating a research question, planning data collection, field methods for collecting data, how to analyse data in the appropriate manner and how to communicate those results both verbally and in a written report. Fieldwork involves completing a research project in groups.
APES3081A Research Methods in Animal, Plant and Environmental Sciences III (12
credits)
This course is a self-study module offered by various staff within the School of Animal, Plant and Environmental Sciences. Students will engage with the staff member about a specific research topic of interest, and develop the research problem statement, aim and objectives with a staff member. The student will then research appropriate methods, conduct the research, and write a report. The course will have a strong focus on research methodology, and skills development (writing and presenting, data collection and analysis).
2026 Timetable
A Statistics for the Natural Sciences STAT2013 (12 points)
C Animal Form and Function II
APES2033A (24 points)
D Ecology, Environment and Conservation IIA
APES2039A (24 points)
E Life on Earth: Diversity II APES2042A (24 points)
Plant Form and Function II APES2041A (24 points)
Ecology, Environment and Conservation IIB
APES2040A (24 points)
Life on Earth: Evolution II APES2043A (12 points)
A Applied Ecology and Global Change IIIA: Individuals, Populations and Communities
APES3082A (30 points)
B Biodiversity in a Changing World IIIA: From Process to Pattern APES3078A (30 points)
Elective courses:
Applied Ecology and Global Change IIIB: Managing our Complex World APES3083A (30 points)
Biodiversity in a Changing World IIIB: From Physiology to Behaviour APES3079 (30 points)
APES3081A Research Methods in Animal, Plant and Environmental Sciences III (12 credits)
APES3084A Practical Skills in Animal, Plant, and Environmental Sciences III (12 credits)
Honours in Animal, Plant and Environmental Sciences
The School offers a fourth year of training in a range of subject areas, which focus more on developing research and analytical skills. The Honours degree is the minimum requirement needed to work and register as a professional scientist. The degree is offered over one-year full-time study.
The Honours degree comprises of:
• An enabling skills course, including training on research methods and statistical analyses.
• One research project with written and oral components.
• Three elective theory topics.
The elective theory topics that may be offered include:
Advances in Microbial Community
Ecology
Analyses of Wildlife Populations
Animal Behaviour and Ecology
Biocontrol
Biogeography
Climate Change: Exploring Science with Society
Conservation Endocrinology
Ecological Engineering and Phytoremediation
Ecophysiology
Ethnoecology
Global Change Impacts on Medicinal Plants
Global Change Impacts on Soils, Plants & Animals
Pollination and Regeneration
Population conservation
Science of Freshwater Management
South African Plant Identification
Spatial Methods in Ecology
Transitions in Environmental Sustainability
Tropical Studies in Field Ecology
Urban Insects: Biodiversity, Ecology, and Conservation
Masters and Doctoral degrees in Animal, Plant and Environmental Sciences
The School has staff members with a range of expertise and experience in supervising postgraduate students and has well-equipped and well-run laboratories. MSc and PhD degrees are usually attained by research work and a dissertation or thesis.

ACADEMIC STAFF
PARRINI, F
ALEXANDER, G
ALMEIDA, RF
ARCHIBALD, S
BALKWILL, K
CONRADIE, S
DUKHAN, S
ENGELBRECHT, HM
FISHER, J
FURNISS, D
GLENNON, K
GOODMAN-CRON, G
MSc (Firenze) PhD (Witwatersrand)
Associate Professor and Head of School
BScHons MSc (Natal) PhD (Witwatersrand)
BSc MSc PhD (Uni Est De Feira De Santana)
Associate Professor and Botanical Curator
BSc (Witwatersrand) BScHons MSc (UCT) PhD (Witwatersrand)
Professor (NRF ‘A’ rated)
BScHons HDipEd(PG) (Witwatersrand)
PhD (Natal) MPhil Theol. (St Augustine)
Emeritus Professor
BSc MSc PhD (Pretoria)
Senior Lecturer
BSc (Natal) BScHons (Durban-Westville)
MSc PhD (Witwatersrand)
Associate Professor
BScHons MSc PhD (Stellenbosch)
Senior Lecturer
BScHons MSc PhD (Witwatersrand) Senior Lecturer
BScHons (Witwatersrand)MSc (UKZN)
MSc PhD (Witwatersrand) Lecturer
PhD (George Washington University)
Associate Professor
BScHons MSc PhD HDipEd(PG) (Witwatersrand)|
Honorary Associate Professor
HARRISON, J
IQBAL, S
MADIKIZA, K
MARSHAL, J
MATIMOLANE, M
MOTITSOE, S
MUVENGWI, J
MYCOCK, D
NOAKES, MJ
OWEN-SMITH, RN
PILLAY, N
REYNOLDS, C
RICHARDS, H
BSc (Witwatersrand) BScHons MSc PhD (Pretoria) Pr. Nat. Sci. (Zoology)
Lecturer and Zoological Curator
BScHons MSc PhD (Witwatersrand) Lecturer
BScHons MSc (University of Fort Hare) PhD (Witwatersrand)
Senior Lecturer
BSc (Alaska) MSc (Alberta) PhD (University of Arizona)
Associate Professor
BSc (Venda) BScHons (Natal) MSc PhD (Witwatersrand) HED (Venda)
Principal Tutor
BScHons (UFS) MSc (Rhodes) PhD (Rhodes)
Senior Lecturer
BSc (BUSE) MSc (UZ) PhD (Witwatersrand)
Associate Professor
BScHons PhD (Natal)
Emeritus Professor
BScHons (UP) MSc (UP) PhD (UP) Lecturer
BScHons MSc (Natal) PhD (Wisconsin) Distinguished Professor (NRF ‘A’ rated)
BScHons MSc PhD (Natal) Professor
BScHons MSc (Witwatersrand) PhD (Cape Town)
Associate Professor
BScHons MSc (Stellenbosh) PhD (Western Cape)
Senior Lecturer (50% with School of Chemistry)
RISENGA, I
SCHOLES, M
SCHWAIBOLD, U
SITUNGU, S
SKELTON, R
TWALA, T
TWINE, W
VENTER, N
VOGEL, C
WITKOWSKI, ETF
WOODFORD, DJ
BSc (Limpopo) BScHons MSc (UJ) PhD (Witwatersrand)
Senior Lecturer
BScHons PhD (Witwatersrand)
Professor and SARChi Chair
BScHons PhD (Witwatersrand)
PDM (Witwatersrand)
Senior Lecturer
BScHons PhD (Rhodes)
Senior Lecturer
BScHons (UCT) MSc (UCT) PhD (UCT)
Associate Professor
BScHons MSc PhD (Witwatersrand) Lecturer
BScHons MSc (Witwatersrand) PhD (KwaZulu-Natal)
Associate Professor
Stationed at the Wits Rural Campus
BScHons MSc (Rhodes) PhD (Witwatersrand)
Senior Lecturer
BA Hons MA PhD HDipEd(PG) Professor and Distinguished Scholar Seconded to Global Change and Sustainability Institute
BScHons MSc (Witwatersrand) PhD (Cape Town)
Emeritus Professor
BScHons MSc (UCT) PhD (Canterbury - NZ)
Associate Professor
School of Molecular and Cell Biology (MCB)

A student registered in the School of Molecular and Cell Biology (MCB) will be majoring or intending to major in at least one of the following courses offered at third year level: Applied Bioinformatics III, Biochemistry and Cell Biology III; Genetics and Developmental Biology III; and Microbiology and Biotechnology III. Students may major in two of the four courses offered in the school of Molecular Cell Biology (see above). This requires that the appropriate courses be completed at both second-andthird year levels. Alternatively, students can major in one course from within the school and one major from outside as specified below.
Second year
Students need to achieve a total of 144 credits at the second-year level. Students must get over 55% in Chemistry - if not they will be wait listed. Students wishing to enter the third year of study with two majors in MCB must register for the following:
• MCB IIA: Molecular Processes MCBG 2038A, (48 credits – B and C slot – students attend class on both slots in Semester 1)
• MCB IIB: Cells and Organisms MCBG 2039A, (48 credits – B and C slot – students attend class on both slots in Semester 2)
• MCB IIC: Applications MCBG 2037A (48 credits – A slot – runs throughout the year) – this course is a prerequisite for those doing an MCB Double Major in 3rd year.
Students wishing to enter the third year of study with a single major in MCB and a major in another School (e.g. Chemistry, Physiology) must consult the Heads of Schools to check on timetable requirements and ensure there are no timetable clashes. In this instance students must register for the following:
• MCB IIA: Molecular Processes MCBG 2038A, (48 credits – B and C slot – students attend class on both slots in Semester 1)
• MCB IIB: Cells and Organisms MCBG 2039A, (48 credits – B and C slot – students attend class on both slots in Semester 2)
• MAJOR in another School (48 credits – A slot – runs throughout the year)
*NB: If you majored in any of the older curriculum courses (pre-2022) i.e. MCB IIA: Scientific Practice MCBG2036A and MCB IIB: Concepts MCBG2032A, please consult Mrs Bennett, Prof Mavri-Damelin, Dr Gentle or Prof Cronje for registration advice.
Third year
Students need to achieve a total of 144 credits at the third-year level. Students wishing to obtain two majors in MCB must register for two of the following –
• Applied Bioinformatics III MCBG 3033A (72 credits – A slot)
• Biochemistry and Cell Biology III MCBG 3004A (72 credits – D slot)
• Genetics and Developmental Biology III MCBG 3034A (72 credits – C slot)
• Microbiology and Biotechnology III MCBG 3035A (72 credits – E slot)
Obtaining a mark of below 40% in any course in 2nd or 3rd year will result in exclusion from the course examination. All queries should be referred to the Senior Administrative Officer or the Head of the School of Molecular and Cell Biology.
NB: If you majored in any of the older curriculum courses (pre-2022) i.e. MCB IIA: Scientific Practice MCBG2036A and MCB IIB: Concepts MCBG2032A, please consult Mrs Bennett, Prof Mavri-Damelin, Dr Gentle or Prof Cronje for registration advice.
SCHOOL OF MOLECUAR AND CELL BIOLOGY 2026
Recommended 1st year course combinations leading to MAJOR courses offered by the School of MCB
1ST YEAR (144 CREDITS)
INTRODUCTORY LIFE SCIENCES (ILS)
(BIOL1035A) [B] [D] (36 CREDITS)
2ND YEAR (144 CREDITS)
3RD YEAR
2 MAJORS (144 CREDITS)
CHEMISTRY I
(CHEM1012A)
[A] [B] [E] (36 CREDITS)
MCB DOUBLE MAJOR STUDENTS MUST TAKE:
MCB IIA: MOLECULAR PROCESSES (MCBG2038A) (B & C - Semester 1] (48 CREDITS) + MCB IIB: CELLS AND ORGANISMS (MCBG2039A) [B & C - Semester 2] (48 CREDITS) + MCB IIC: APPLICATIONS (MCBG2037A) [A - Full Year] (48 CREDITS)
BIOCHEMISTRY & CELL BIOLOGY III
(MCBG3004A) [D] (72 CREDITS)
GENETICS & DEVELOPMENTAL BIOLOGY III
MATHEMATICS I Auxiliary
(MATH1041A) [B] [E] (36 CREDITS)
PREFERRED UNITS: PHYSICS I Auxiliary (PHYS1001A) [A] [C]
PSYCHOLOGY (PSYC1001A/1002A) [B/E] (36 CREDITS)
MCB SINGLE MAJOR WITH ANOTHER MAJOR FROM OTHER SCHOOLS IN THE FACULTY OF SCIENCE MUST TAKE:
MCB IIA: MOLECULAR PROCESSES (MCBG 2038A) [B & C - Semester 1] (48 CREDITS) +
MCB IIB: CELLS AND ORGANISMS (MCBG 2039A) [B & C - Semester 2] (48 CREDITS) +
OTHER MAJOR: e.g. Chemistry, Psychology, Anatomy, Physiology etc (48 CREDITS)
(MCBG3034A) [C] (72 CREDITS) MICROBIOLOGY & BIOTECHNOLOGY III
(MCBG3035A) [E] (72 CREDITS) APPLIED BIOINFORMATICS III
(MCBG3033A) [A] (72 CREDITS) 1
MAJOR + ANOTHER MAJOR see above Chemistry, Psychology etc (72 CREDITS)
Second year courses
MCBG2038A MOLECULAR AND CELL BIOLOGY IIA: MOLECULAR PROCESSES (48 credits) (Slots B and C) (Blocks 1-2)
This is a restricted course.
Prerequisites: Introductory Life Sciences I (BIOL 1035A) AND Chemistry I (CHEM 1012A) with 55% minimum mark AND Mathematics I Auxiliary (MATH 1041A) AND another 36-credit course
Co-requisite: Molecular and Cell Biology IIB: Cells and Organisms (MCBG 2039A) AND Molecular and Cell Biology IIC: Applications (MCBG 2037A)[For MCB Double Majors] OR one other 48 credit course
Description:
This course consists of two components, Biological Chemistry & Macromolecules, and Genes & Genomes. The course provides a thorough overview of chemical structures and reactions of functional groups leading to the study of macromolecules from an organic chemistry perspective. The course introduces students to the interplay between DNA, RNA and proteins, as fundamentals to the study of molecular biology. The impact of genome architecture and epigenetics, on DNA transmission, inheritance of genetic traits, transcription and translation will be explored, including relevant statistical analysis such as for population genetics. Students will become acquainted with wet lab methods and bioinformatics tools for DNA analysis and manipulation and for investigating protein structure and function.
MCBG2039A MOLECULAR AND CELL BIOLOGY IIB: Cells and Organisms
(48 credits) (Slots B and C) (Blocks 3-4)
This is a restricted course.
Prerequistes: Introductory Life Sciences I (BIOL 1035A) AND Chemistry I (CHEM 1012A) with 55% minimum mark AND Mathematics I Auxiliary (MATHA 1041A) AND another 36-credit course.
Co-requisite: Molecular and Cell Biology IIA: Molecular Processes (MCBG 2038A) AND Molecular and Cell Biology IIC: Applications (MCBG 2037A)[For MCB Double Majors] OR one other 48 credit course
Description:
This course covers molecular and cell biology at the cellular and organisimal levels. Students will be introduced to key concepts in cell biology by looking at cell structure, signalling and interactions. Students will use thermodynamics and enzyme kinetics to describe the fundamental pathways of intermediary metabolism.
Students will further apply these concepts to learning how dysregulated cellular processes can cause disease, and how cells interact to produce immune responses in human immunology. The second section focuses on the diversity of micro-organisms, including bacteria, viruses and fungi, their ecology and their interaction with their hosts.
Both sections will equip students with fundamental laboratory skills in cell biology and microbiology.
MCBG2037A MOLECULAR AND CELL BIOLOGY IIC: APPLICATIONS
(48 credits) (Slot A) (Blocks 1-4)
This is a restricted course
Prerequisites: Introductory Life Sciences I (BIOL 1035A) AND Chemistry I (CHEM 1012A) with 55% minimum mark AND Mathematics I Auxiliary (MATH 1041A) AND another 36-credit course
Co-requisites: Molecular and Cell Biology IIA: Molecular Processes MCBG 2038A AND Molecular and Cell Biology IIB: Cells and Organisms MCBG 2039A
Description:
This course explores the theory and practical techniques behind the latest research within four broad topic areas. Molecular Basis of Disease investigates the molecular underpinnings and therapeutic approaches of diseases such as cancer and inherited disorders, and focuses on modes of inheritance, epigenetics and gene-environment interactions. Drug Discovery looks at the processes and principles behind identification of drug targets and drug discovery, mechanisms of action and side effects, trials and commercialisation. Current Topics in Microbiology considers the role of viruses, bacteria and fungi in the environment, human health and agricultural biotechnology. Genetic Innovations studies genetics and genomics in forensic science, disease diagnosis, pharmacogenomics and personalised medicine, and considers genetic manipulation for the improvement of human health and the environment.
Third year courses
MCBG3004A BIOCHEMISTRY AND CELL BIOLOGY III (72 credits) (Slot D)
This is a restricted course
Biochemistry and Cell Biology studies the chemistry of life by investigating the structurefunction relationships of life’s building blocks: proteins, carbohydrates, fats, and nucleic acids, and looks at their roles in a range of cellular processes and contexts including during disease and in the immune response. Throughout this course, students will study the theory behind biochemical processes and cellular biology, and this will be complemented with practical skills in these areas, using both wet-lab and bioinformatics techniques. This Major is comprised of the following courses: Advanced Enzymology, Advanced Protein Biochemistry and Biotechnology, Advanced Immunology and Advanced Cell Biology.
Prerequisites: Molecular and Cell Biology IIA: Molecular Processes (MCBG2038A) AND Molecular and Cell Biology IIB: Cells and Organisms (MCB 2039A) AND either Molecular and Cell Biology IIC: Applications (MCBG 2033A) OR one other 48 credit course
If you obtain an overall mark of 50% for a course but have failed more than half the credit value for that course, you will be required to repeat the following year. A mark of below 40% for any component will result in exclusion from that examination.
PROTEIN BIOCHEMISTRY AND BIOTECHNOLOGY III
This course provides the students with an in-depth appreciation for protein structure and stability. It focusses on interpretation of data and skills both in the wet lab and in silico. The outline of the course includes: An overview of properties and functions of amino acids, peptide and proteins; molecular forces; Protein primary, secondary, tertiary and quaternary structures. Protein structure determination methods; Protein folding, dynamics and conformational stability. Protein structure-function relationships and motifs. In vitro mutagenesis and protein engineering. Protein Biotechnology, the large-scale production of native and recombinant proteins, and the utilisation of proteins in medicine and industry.
ADVANCED CELL BIOLOGY III
This course aims to demonstrate how the contemporary field of cell biology has developed through the integration of structural, and biochemical studies that have most recently been revolutionised by the understanding at the molecular level of gene structure and function. The discussion will lead to an understanding of how cells contain highly organised biochemical systems that lead ultimately to the formation of the fundamental molecular components of all living organisms. The course explores the interrelationship of molecules central to the establishment of cellular life and thus provides a detailed understanding of the signals and constraints responsible for the regulation of cell proliferation. Exploring the concepts underlying how cells are continually replaced from undifferentiated self-renewing stem cells will inform an in-depth interrogation of how differentiated cells maintain their specialised character, and cancer cells proliferate in defiance of normal controls.
ENZYMOLOGY III
This course focusses on the study of enzymes and will provide the student with an introduction to enzymology. This is achieved by means of lectures and computerbased enzymology laboratory sessions (using alkaline phosphatase as a model enzyme).


The course is designed to equip the student with a fundamental understanding of enzymology in the following areas: enzyme techniques; chemical kinetics; mechanisms of enzyme catalysis; enzyme regulation and application of enzymes in biotechnology.
ADVANCED IMMUNOLOGY III
This course explores advanced topics in Immunology. It provides an overview of the function and regulation of innate and adaptive immunology in humans and presents a selection of recent developments and advanced applications of immunology in various fields including infectious and non-infectious diseases such as immunotherapy and other innovations. It also introduces the fields of vaccinology, including vaccine design and evaluation, wetlab methods and various techniques used to investigate the function, development and regulation of the immune response
MCBG3034A GENETICS AND DEVELOPMENTAL BIOLOGY III (72 credits) (Slot C)
This is a restricted course
Genetics and Developmental Biology looks at the roles and functional significance of genes and genomes at the molecular, cellular and organismal levels. The course builds on the fundamental concepts and theories covered at the second year, then explores these further by applying them to a range of advanced processes such as developmental biology; understanding inheritance of genetic traits; the development and prediction of disease and therapeutic approaches from the cell to and population levels. Throughout this course, these topics will be complemented by a range of practical skills in these areas, including both wet-lab and bioinformatics techniques. This Major is comprised of the following courses: Gene Regulation in Eukaryotes, Population Genetics, Genomes and Genomics and Advanced Developmental Biology.
Prerequisite: Molecular and Cell Biology IIA: Molecular Processes (MCBG2038A) AND Molecular and Cell Biology IIB: Cells and Organisms (MCB 2039A) AND either Molecular and Cell Biology IIC: Applications (MCBG 2033A) OR one other 48 credit course
If you obtain an overall mark of 50% for a course but have failed more than half the credit value for that course, you will be required to repeat components the following year. A mark of below 40% for any component will result in exclusion from that examination.
GENE REGULATION IN EUKARYOTES III
This course focuses on the mechanisms that contribute to regulating gene expression in eukaryotes. The material covered starts at the level of DNA structure, which includes looking at the contribution of epigenetic modifications. This is followed by transcription initiation with an examination of the components responsible for modifying gene expression, such as DNA promoter elements and transcription factors. Then, the mechanisms involved in RNA processing are discussed with a focus on their influence on protein expression. Finally, the signalling cascade of events that modify gene regulation and expression will be placed into context using examples from various cellular processes, such as those in development and disease.
POPULATION GENETICS III
This course will be a general introduction to the field of population genetics, which has become an integral component of genomics, medical genetics, forensics, conservation biology and bioinformatics. Particular topics to be dealt with in detail include processes that affect frequencies of alleles, haplotypes and genotypes in populations over time, and departures from Hardy Weinberg equilibrium. Quantitative genetic variation and genetics of complex traits, heritability, selection and evolutionary genetics will be discussed. We will explore advanced and current molecular genetic techniques to detect different kinds of genetic variation for use in population genetics applications.
GENOMES AND GENOMICS III
This course focuses on the role of Genomes and Genomics in modern science. It provides a thorough overview of genome architecture and function, from genome structure to central dogma, and examines the role of genomics in the analysis of genomes, with a focus on human and other mammalian genomes. It explores the theory behind, and the impact of, new technologies, such as next-generation sequencing and transcriptomics, and looks at how these are applied to analyse genomes, for example in disease diagnosis and treatment, and introduces wet-lab methods and bioinformatics tools for genome analysis and the various genomic technologies used to investigate the structure and function of genomes.
ADVANCED DEVELOPMENTAL BIOLOGY III
In this course students are introduced to the exciting field of modern Developmental Biology. The course encompasses exploration of the morphological, molecular and genetic processes that are responsible for vertebrate embryogenesis, as well as how these processes are altered during evolution or in congenital disease. Formation of several vertebrate anatomical structures (e.g. limbs, reproductive system) is discussed in depth. Additionally, students are provided with an overview of the exciting fields of aging and regenerative medicine.
MCBG3035A MICROBIOLOGY AND BIOTECHNOLOGY III (72 credits) (Slot E)
This is a restricted course
Microbiology and Biotechnology is the study of microbes that include bacteria, viruses, yeasts and fungi. Throughout this Major, students will look at the various groups of microbes, their morphology, metabolism, genetics and taxonomy. The functional significance of these microbes is studied across various fields, including environmental biotechnology, industrial microbiology, plant genetic engineering and food and medical microbiology. Students will study both the background of these organisms as well as gain practical experience in a range of microbiological methods using wet-lab skills and bioinformatics. This Major is comprised of the following courses: Advanced Bacteriology, Advanced Virology, Biotechnology of Fungi, Microbial Food Security, Plant and Invertebrate Pathology, and Biotechnology and Engineering.
Prerequisite: Molecular and Cell Biology IIA: Molecular Processes (MCBG2038A) AND Molecular and Cell Biology IIB: Cells and Organisms (MCB 2039A) AND either Molecular and Cell Biology IIC: Applications (MCBG 2033A) OR one other 48 credit course
If you obtain an overall mark of 50% for a course but have failed more than half the credit value for that course, you will be required to repeat components the following year. A mark of below 40% for any component will result in exclusion from that examination.
ADVANCED VIROLOGY III
This topic will cover principles of virus-host interactions and pathobiology with respect to human and animal viruses, with specific emphasis on the host immune response. Included in this will be the strategies employed by the different viruses to subvert the host immune response. We will also address virus evolution in some detail, and in that context, try and understand the emergence of new viral diseases such as HIV/AIDS and SARS.
ADVANCED BACTERIOLOGY III
This course is designed to provide students with an overview of the unique characteristics of bacteria and their interactions with other organisms in the environment. The course reviews bacterial metabolism and growth, bacterial attachment to surfaces and the formation and characteristics of bacterial biofilms. The course also explores bacterial infections of mammalian hosts, pathogenesis and virulence factors. Key concepts relating to interbacterial communication and coordinated population responses are reviewed.
PLANT AND INVERTEBRATE PATHOLOGY III
Plant pathogens and pests cause considerable crop losses world-wide. The course introduces students to the key group of insect and plant pathogens. In addition to reviewing insect defences to pathogens, the methods of infection, disease development and transmission of the different groups of insect pathogens are studied. The course will also cover the principles of insect biocontrol. Plant pathology topics include disease identification (as part of practicals) and the molecular basis of susceptibility and resistance of plant hosts. The outcomes are an understanding of plant and insect pathogens and their interactions with their hosts.
BIOENGINEERING & BIOTECHNOLOGY III
This course introduces the student to the key concepts underlying selected topics in Bioengineeering and Biotechnology. The course involves the critical analysis of the design, development, operation and optimization of bioprocesses for the production of various high value ‘bioproducts’. In this course the use of algae, yeasts, fungi and bacteria for the production of high valued products such as biomethane, bioethanol, biohydrogen, biodiesel, bioplastics, antibiotics, insecticides, biofertilizers, pharmaceuticals and fine chemicals will be discussed. In addition, the use of bacteria in bioleaching (application of bacterial to extract minerals), bioremediation (acid mine drainage and organic chemical pollution) and crop pest control (the entomopathogenic nematode-bacterial-host complex) will be investigated. Also, in this course the applications of various bioprocess and bioreactor technologies such as continuous stirred tank bioreactors, fluidized bed bioreactors, air lift bioreactors and photobioreactors will be described. The course will be comprised of lectures, laboratory-based practical’s and computer lab.


MICROBIAL FOOD SECURITY III
Modern concepts in food preservation and food safety and quality management will be reviewed. The concept of hurdle technology and its application in food preservation will be illustrated. Modern approaches to achieving food safety and stability by applying hygiene management and the Hazard Analysis Critical Control point (HACCP) system will be explained and illustrated. The concept of quantitative microbial risk assessment and its application to international food trade will be reviewed and explained.
BIOTECHNOLOGY OF FUNGI III
This course provides an overview of the use of fungi in the biotechnology of the food industry; the production of biochemicals; in medical biotechnology; agricultural biotechnology; environmental biotechnology; and bioremediation. Detailed aspects cover the use of yeasts and fungal cell wall-degrading enzymes in the food industry; the use of white-rot fungi in the pulp and paper industry; fungi and the biodegradation of industrial and mining wastes.
MCBG3033A APPLIED BIOINFORMATICS III (72 credits) (Slot A)
This is a restricted course.
Applied Bioinformatics uses various tools to study and interpret computational results generated from biological experiments. In this Major course, students will develop the ability to identify the appropriate bioinformatics tool for the task at hand; explain the underlying theory behind these tools; demonstrate the utility of different computational approaches; compare databases and portals; assess the limitations of algorithms and tools; and evaluate results of bioinformatics experiments Students will also develop an appreciation of the breadth and shortcomings of available computational approaches. The Major course is comprised of the semester course Introduction to Bioinformatics III and the student must also select one semester of courses from any other MCBG III major that does NOT form part of their other MCBG III major.
Prerequisite: Molecular and Cell Biology IIA: Molecular Processes (MCBG2038A) AND Molecular and Cell Biology IIB: Cells and Organisms (MCB 2039A) AND either Molecular and Cell Biology IIC: Applications (MCBG 2033A)
Compulsory: Introduction to Bioinformatics III (36 credits) in Blocks 3 & 4, Slot A; AND a semester 1 choice from one other Molecular and Cell Biology III major NOT included in the second MCB major. NB: These courses must fit into available slots in the student’s timetable, which is especially important to note if the other major is not within MCB. If you obtain an overall mark of 50% for a course but have failed more than half the credit value for that course, you will be required to repeat components the following year. A mark of below 40% for any component will result in exclusion from that examination.
INTRODUCTION TO BIOINFORMATICS III
Introduction Bioinformatics is a 36 credit course that currently takes place in Semester 2. Students taking the Applied Bioinformatics major are therefore required to take an additional 36 credits by taking semester 1 courses from one of the other MCB majors: these will be credited to the Applied Bioinformatics major to attain the required 72 credits. The overall aim of the course is for students to understand the utility of bioinformatics in the scientific field. Students will learn to select, describe and use basic bioinformatics tools and how to interpret computational results. Students will also develop an appreciation of the breadth and shortcomings of available computational approaches. Students should develop the ability to identify the appropriate bioinformatics tool for the task at hand; explain the underlying theory behind these tools; demonstrate the utility of different computational approaches; compare and contrast databases and portals; assess the limitations of algorithms and tools; evaluate results of bioinformatics experiments.
Possible fields of employment with a degree from the School of Molecular and Cell Biology:
Academic: Teaching and/or research at universities
Research: Animal and plant breeding at institutions such as the Onderstepoort, the South African National Biodiversity Institute, Agriculture Research Council.
Medical research can be carried out at the Council for Scientific and Industrial Research (CSIR), the National Health Laboratory Services (NHLS), National Institute for Communicable Diseases (NICD), amongst others. A degree can be used as a foundation for moving into other medically related fields such as genetic counselling and opportunities at the Departments of Health.
Private enterprise: Many private companies such as seed producers, breweries and agricultural companies, the dairy and food industries, water purification, pharmaceutical and chemical companies require graduates with majors in the fields of Molecular and Cell Biology.
POSTGRADUATE DIPLOMA IN SCIENCE IN THE FIELD OF APPLIED BIOSCIENCES
This is a restricted course
A Postgraduate Diploma is a fourth year of training and is the minimum requirement needed to work as a professional scientist. This course is aimed at those that seek a career in industry, as opposed to research. This Diploma is comprised of the following courses:
Professional Skills in Industry Practice provides skills are essential in the workplace, especially in industry. This course will introduce students to skills that they will encounter in various work settings from food and beverage to pharmaceutical industries. The skills include basic training in safety and risk; budgets and finance affairs; project design and planning; quality control and accreditation processes; data management; ethics and intellectual property considerations.
Microbial Food Safety and Quality Control is critical to various industries, including the food and beverage industry. In this course students will use various microbiological techniques to analyse and determine microbial contamination, as well as perform basic identification of microorganisms.
Bioanalytical Techniques are central to the workings of any molecular and cellular biology laboratory. This course will first introduce students to fundamental laboratory equipment such as balances and centrifuges that are essential in any laboratory. The course then covers the theory and practice of key analytical skills such culture, extractions and electrophoretic techniques. Lastly, the course will look at ways to analyse, present and interpret data, including fundamental statistical analysis.
Molecular Analysis and Diagnostics is at the forefront of science and explores how molecular biology methods are used to aid in diagnosis. Students will cover the theory behind various methods in detail, such as polymerase chain reaction and next generation sequencing. Next students will look at how these various methods are applied, including pathogen detection and identification, identification of genetic disorders, pharmacogenomics and personalised medicine, diagnosing and subsequently treating cancer, and in forensic DNA analysis. In addition, student will perform various molecular wet and dry lab techniques including relevant bioinformatics analysis.
Chemical Analysis for Industry looks at the theory and practice of a range of chemical analysis methods. Students will become well acquainted with various aspects of chemical analysis, including handling samples, to selecting the most appropriate method of analysis, carrying out the methods and interpreting the data acquired.
Enzyme Technology for Industrial Applications explores the varied uses of enzymes in industry. This course starts with an introduction to the basic structure and function of enzymes, then moves onto methods of enzyme production. The course then focuses on the use of enzymes including their uses in the food and beverage industry, pharmaceutical and medical sectors and in the environment and waste management.
All together, these courses fulfill the main purpose of the postgraduate diploma, which is to offer a course that offers skills that are common in various industries and as such increase employment opportunities.
HONOURS IN MOLECULAR AND CELL BIOLOGY
This is a restricted course. Honours is a fourth year of training and is the minimum requirement needed to work as a professional scientist. Honours in the School of Molecular and Cell Biology will allow you to specialize in one of four disciplines, namely Applied Bioinformatics, Biochemistry and Cell Biology, Genetics and Developmental Biology or Microbiology and Biotechnology.
Duration
One academic year of full-time study.
Honours in Biochemistry and Cell Biology (120 Credits)
The candidate must complete the following compulsory courses to qualify for a BSc Honours in the field of Biochemistry and Cell Biology.
Honours in Genetics and Developmental Biology (120 Credits)
The candidate must complete the following compulsory courses to qualify for a BSc Honours in the field Genetics and Developmental Biology.
Honours in Microbiology and Biotechnology (120 Credits)
The candidate must complete the following compulsory courses to qualify for a BSc Honours in the field of Microbiology and Biotechnology.
Honours in Applied Bioinformatics (120 Credits)
The
Honours in the field of Applied Bioinformatics
a
NOTE: Students must obtain a pass in all three compulsory courses in order to pass
ACADEMIC STAFF
CRONJÉ, MJ
ACHILONU, I
BOTES, A
BOUWER, G
BUTHELEZI, S
DAMELIN, L
DE ASSIS ROSA, D
DE MAAYER, P
FANUCCHI, S
GENTLE, N
HAYAT, M
JIVAN, R
KAUR, M
LEPHOTO, T
BSc (RAU), BSc Hons Biochemistry (UFS), BSc Hons Zoology (UFS), MSc (UFS), PhD Biochemistry (UJ) Head of School: Molecular & Cell Biology
MSc UKZN PhD UKZN
Associate Professor (Biochemistry & Cell Biology)
BSc Hons MSc PhD (Stellenbosch)
Senior Lecturer (Microbiology & Biotechnology)
BSc Hons MSc PhD (Witwatersrand)
Associate Professor (Microbiology & Biotechnology)
BSc Hons MSc PhD (Witwatersrand) Lecturer (Biochemistry & Cell Biology)
BSc Hons MSc PhD (Witwatersrand)
Senior Lecturer (Microbiology & Biotechnology)
BSc Hons MSc PhD (Witwatersrand)
Senior Lecturer (Genetics & Developmental Biology)
BSc Hons (Witwatersrand) MSc (Ghent) PhD (Pretoria)
Associate Professor (Microbiology & Biotechnology)
BSc Hons MSc PhD (Witwatersrand) Senior Lecturer (Biochemistry & Cell Biology)
BSc Hons MSc PhD (Witwatersrand) Senior Lecturer (Applied Bioinformatics)
BSc Hons MSc PhD (Witwatersrand) Lecturer (Genetics & Developmental Biology)
BSc Hons MSc PhD (Witwatersrand) Senior Lecturer (Genetics & Developmental Biology)
BSc Hons MSc (Guru Nanak Dev Univ) PhD (Punjabi Univ) Professor (Biochemistry & Cell Biology)
BSc Hons MSc PhD (Witwatersrand) Lecturer (Microbiology & Biotechnology)
MAVRI-DAMELIN, D
MEYER, V
NIKITINA, N
PAXIMADIS, M
SAYED, Y
SIBANDA, T
VAN DER MERWE, E
XULU, K
BSc Hons (Herts, UK) MSc PhD (Univ College London, UK)
Associate Professor (Genetics & Developmental Biology)
BSc Hons MSc PhD (UJ)
Senior Lecturer (Biochemistry & Cell Biology)
BSc Hons MSc (Wits) PhD (UCT)
Associate Professor (Genetics & Developmental Biology
BSc Hons MSc PhD (Witwatersrand)
Senior Lecturer (Genetics and Developmental Biology)
BSc Hons MSc PhD (Witwatersrand)
Professor (Biochemistry & Cell Biology)
BSc Hons (MSU, Zim) MSc PhD (UFH, RSA), PDHE (UNAM, Nam)
Associate Professor (Microbiology & Biotechnology
BSc Hons MSc PhD (UJ)
Senior Lecturer (Biochemistry and Cell Biology)
BSc Med Hons, MSc Med (UCT), PhD (SU) Lecturer (Genetics and Developmental Biology)
School of Biomedical Sciences, Department of Physiology

Prerequisites for PHSL 2000A are:
Introductory Life Sciences I (BIOL 1035A; a minimum pass mark of 55% is required) AND Chemistry I (CHEM1012A) AND ONE OF Physics I (Auxiliary) (PHYS1001A), Mathematics (Auxiliary) (MATH1041A)
The course will cover the physiology of key body systems as listed below:
Blood and body fluids
Basic fluid physiology, and haemotology.
Excitable tissues
Neuromuscular physiology, synaptic function, and the functioning of the autonomic nervous system.
Cardiovascular system
The basic principles of cardiac function and the circulation of blood.
Respiratory function
The basic mechanisms of ventilation, gas exchange, gas transport, regulation of respiration.
Renal function
The renal regulation of electrolyte and water balance.

Acid-base regulation. Include the following supporting text: The renal and respiratory regulation of acid-base status.
The regulation of body temperature through changes in heat loss and heat gain mechanisms under various environmental and physiological states.
Central nervous system
The principles of the sensory nervous system, including special senses (e.g., vision, hearing), the control and initiation of movement, and higher functions of the central nervous system (e.g., memory, language).
Gastrointestinal tract and nutrition
An overview of the transport, digestion, absorption, and excretion functions of the gastrointestinal tract, and the use of nutrients.
Endocrine physiology
An overview of endocrine glands and the hormones they secrete, the function of these hormones, and feedback control mechanisms for these hormones.
Energetics and Exercise
Intermediary metabolism, and the physiology of exercise.
PHSL3006A HUMAN PHYSIOLOGY III (72 credits) (Slot A)
Prerequisite: Physiology II (PHSL2000A); Physiology & Medical Biochemistry I (PHSL2004A)
The course assumes Physiology II knowledge and follows a set curriculum consisting of a selection of physiology topics based on the research interests in the School of Physiology, and a research assignment. A bouquet of the potential topics which may be included are listed below. For each topic, the content may vary annually.
Principles of experimental physiology
The topic introduces students to aspects of experimental design, the ethics of animal and human experimentation, and statistical analysis methods.
Cardiovascular physiology
Examples of subjects covered include physiological approaches to understanding abnormal electrocardiographs (ECGs), the pathophysiology of cardiac failure, and the haemodynamics and pathophysiology of altered blood pressure (hypertension and shock).
Respiratory physiology
Examples of subjects covered include the physiological consequences of defects in lung ventilation (obstructive and restrictive defects) and perfusion, and respiratory failure.
Body fluid balance
Examples of subjects covered include disturbances to body fluid homeostasis (e.g., dehydration and overhydration), capillary membrane abnormalities, pathophysiology of kidney disease, assessment of kidney function, acute and chronic renal failure, physiological basis of fluid therapy, and the principles of body acid-base balance.
Neurophysiology
Examples of subjects covered include neurotransmitters and their function, pain, itch, memory, sleep, circadian rhythms, and addiction.
Gastrointestinal physiology and nutritional disorders
Examples of subjects covered include disturbances to the gastrointestinal system in the context of macro and micronutrient components of a balanced diet, appetite regulation, weight control, digestion, malnutrition, absorption and metabolic processes, and the physiology of the gut microbiome.

Immunology and inflammation
Immunology and Inflammation
Examples of subjects covered include the physiology of signal transduction and the function of the immune system, and the pathophysiology of the immune system in various diseases and auto-immune disorders. It also may include basic techniques of molecular technology used in immunology including antibody-based analysis of proteins and the in vivo analysis of gene function.
Thermal physiology
Examples of subjects covered include the physiological response to thermal stress and the techniques used to measure core body temperature, and the physiological mechanisms through which heat gain and heat loss occurs during change in the environment or physiological state (e.g., during fever).
Exercise physiology
Examples of subjects covered include the physiology of exercise to integrate the functions of the cardiovascular system, the respiratory system, temperature regulation, and muscle function.
Pregnancy and neonates
Examples of subjects covered include the physiology of reproduction and the failure to reproduce, and sex determination and differentiation. The physiology of neonates during the first 28 days of life also may be covered.
Research Assignment
A three-week assignment involving the analysis of experimental data and the writing of a research report based on the analysis.
ACADEMIC STAFF
BESTER, J
BAIJNATH, S
BROOKSBANK, R
CHIVANDI, E
DAFKIN, C
DANIELS, W
DLAMINI, S
ERLWANGER, K
FAKO, K
FULLER, A
HARDEN, L
KAMERMAN, P
KGOADI, K
GREEN, K
Professor and Head: Department of Physiology, School of Biomedical Sciences
Hons (UP), MSc (UP), PhD Human Physiology (UP)
B Med Sci, B Med Sci (Hons), M Med Sci, PhD (University of KwaZulu-Natal)
Associate Professor
BSc Hons, MSc, PhD (Witwatersrand) Associate Professor
BSc Hons (Zim), MSc (Malawi), PhD (Witwatersrand), P.G.Dipl.Health Sci. Edu. (Wits) Professor
BSc Hons, PhD (Witwatersrand) Senior Lecturer
PhD, MBA (Stellenbosch) Professor
BSc, BSc(Hons), MSc (UKZN), PhD (Wits) Lecturer
BVSc (Zim), MSc (Edinburgh), PhD (Zim), PGDip. Health Sci. Edu. (Wits) Professor
BHSc Hons, MSc (Wits) Academic Support Officer
BSc Hons, PhD (Witwatersrand) Professor
BA Hons (Pretoria) MSc, PhD (Witwatersrand) Associate Professor
BSc Hons, PhD (Witwatersrand) Professor
BSc (UJ), BSc (Hons), MSc (UP), PhD (UCT) Lecturer
BSc (Wits), BHSc Hons (Wits) Associate Lecturer
KALULA, G
KISTEN, T
KOLKENBECK-RUH, A
LUBBE, A
MADZIVA, M
MANILALL, A
MASEKO, J
MICHEL, F
MILLEN, A
MKANDLA, Z
NTLANE, R
PETERSON, V
PILLAY, P
POWRIE, Y
SCHEUERMAIER, K
TADE, G
VELIOTES, D
BSc, BSc (Hons), MSc (UP) cademic Support Officer
BSc Hons (Biokinetics), MSc, PhD (UKZN) Lecturer
BSc, BHSc Hons, MSc (Med), PhD (Witwatersrand) Senior Lecturer
BHSc (NWU), BHSc Hons (Wits), MSc Med (Wits) Associate Lecturer
BPharm (Zim), MSc (Bristol), PhD (Cambridge) Lecturer
BSc Hons, MSc, PhD (Witwatersrand) Researcher
BSc Hons (UNIN), MSc, PhD (Witwatersrand)
Associate Professor
BSc, MSc, PhD (France)
Associate Professor
BScHons, MSc (Stellenbosch), PhD, MBA (Witwatersrand) Professor
B. Biomed. Tech, M. Biomed. Tech (CPUT), PhD (UKZN) Lecturer
BSc (UP), BMedSci Hons (UKZN), MSc Med (Witwatersrand)
Academic Support Officer
BSc Hons, MSc, PhD (Witwatersrand) Associate Professor
BSc, BSc(Hons), MSc, PhD (Witwatersrand) Lecturer
MSc, PhD (Stell) Lecturer
MBBCh (Paris) Associate Professor
BSc (Hons) (Babcock University), MSc (Ibadan, Nigeria), PhD (Wits) Lecturer
BSc, BSc Hons, MBBCh, PhD (Witwatersrand), FC Neurology (S.A)
Senior Lecturer/Consultant Neurologist (Helen Joseph Hospital)
WOODIWISS, A
BSc (Physio), MSc, PhD (Witwatersrand) Professor

